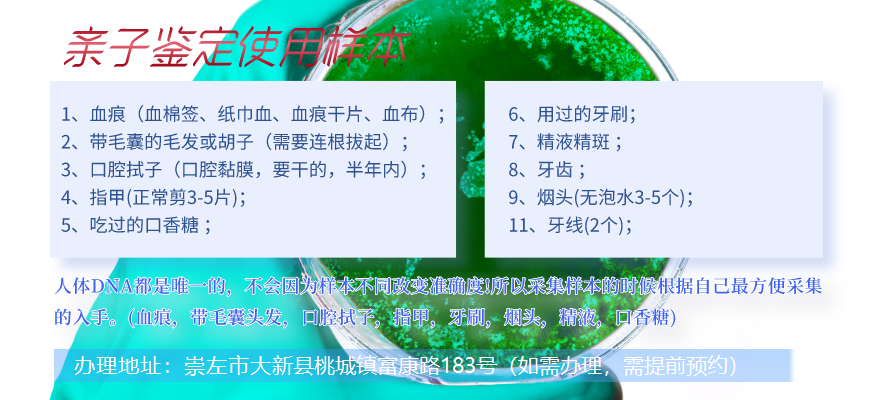

當今社會,科技的進步,懷孕期間孕婦親子鑒定也成為一種方便的手段,但有些大新用戶會擔心做孕期親子鑒定會對胎兒有影響,畢竟采集胎兒絨毛和羊水是手術取樣,多少會有一定的風險。而無創DNA親子鑒定的出現,則規避了這種風險。
大新孕期胎兒親子鑒定中心
懷孕期間孕婦親子鑒定辦理地址:崇左市大新縣桃城鎮富康路183號(如需辦理,需提前預約),大新服務地區包括:江州區、扶綏縣、寧明縣、龍州縣、大新縣、天等縣、憑祥市等大新周邊城市。
可在線咨詢:懷孕期間孕婦親子鑒定、司法親子鑒定、移民親子鑒定、入戶親子鑒定、中考報告親子鑒定、高考親子鑒定、個人隱私親子鑒定等等咨詢服務,萬核親子鑒定咨詢服務機構,聯合了多家權威法醫物證司法鑒定及基因檢測公司的親子鑒定服務咨詢機構,采用先進的DNA檢測技術,確保鑒定結果的準確性和可靠性。

懷孕期間孕婦親子鑒定多少錢一次
作為一家專業的親子鑒定機構,大新萬核親子鑒定服務機構的服務項目涵蓋了司法親子鑒定、個人親子鑒定、親緣關系鑒定、個體識別鑒定、上戶親子鑒定和懷孕期間孕婦親子鑒定等多種服務。這些服務覆蓋面廣泛,能夠滿足不同客戶的需求,為其提供全方位的鑒定服務。
比如,在司法親子鑒定方面,大新萬核親子鑒定服務機構可以根據檢案需求提供各種類型的樣本,如口腔黏液、血液、頭發和指甲等等,根據實際情況選擇合適的樣本進行鑒定,確保鑒定結果的準確性。這樣的服務能夠為司法機關提供可靠的鑒定結果,維護司法公正性和社會公正性。
同時,大新萬核親子鑒定服務機構還可以提供懷孕期間孕婦親子鑒定服務,以滿足用戶日常親子鑒定的需求。產前鑒定價格一般在4000-5000元之間,鑒定周期為5-7個工作日,可以讓客戶及時獲得結果,在緊急情況下提供快速服務。這樣的服務,不僅保護了客戶的個人資料隱私,還讓用戶在方便快捷的同時享受到高質量的服務。
最后,大新萬核親子鑒定服務機構作為專業的親子鑒定機構,一直堅持以客戶需求為中心,為客戶提供最佳的鑒定方案,讓用戶享受到優質的服務。
懷孕期間孕婦親子鑒定規定要求
懷孕期間孕婦親子鑒定是一種非侵入性的親子鑒定方式,具備無疼、迅速、精確等特點。為了能確保鑒定報告的穩定性,下列大新萬核親子鑒定服務中心就懷孕期間孕婦親子鑒定的需求:
1.必須父親或母親的血液。在其中孕婦要給予靜脈血樣本,而男性可以考慮給予血夜、秀發、手指甲、煙蒂等幾種樣本,確保鑒定報告準確性。
2.采樣前必須在線咨詢萬核。采樣之前需要在線咨詢萬核基因采樣方式以及相關標準。
3.采樣前必須防止健身運動。采樣之前需要防止運動過量,以防止對血液成分產生的影響。
4.采樣時要維持身體釋放壓力。采樣時要保持身體釋放壓力,不要過度焦慮不安和不安,以確保樣本準確性。
5.采樣時特別注意環境衛生。采樣的時候需要注意環境衛生,防止污染互相污染,確保樣本的純粹性。
6.采樣后應及時復檢。采樣后應該及時復檢,防止樣本霉變危害鑒定報告。
7.挑選可信賴的鑒定中心。必須選擇一家、技術專業、具備資格的鑒定中心,確保鑒定報告準確性和可靠。
8.保護個人信息。鑒定中心必須保護個人信息,確保鑒定報告的安全性。

進行懷孕期間孕婦親子鑒定以前,大家應注意一些事宜細節。
最先,一定要找到正規親子鑒定鑒定專業機構鑒定,以確保鑒定過程的可靠性。
次之,在開展前期準備工作時,必須遵照大新萬核親子鑒定服務中心人員的具體指導,按照規定填寫信息并收集血樣。在收集血樣的過程當中,必須注意個人衛生與安全,以防止造成傷害。
最終,在接到鑒定結論后,必須謹慎處理并保管好,以防泄露個人隱私信息。細心地提前準備及注意事項,能夠確保懷孕期間孕婦親子鑒定準確性和可靠性,更能給您和你的家人健康和美好產生確保。
無創懷孕期間孕婦親子鑒定多長時間結果出來?
正常的申請辦理懷孕期間孕婦親子鑒定的情形下一般是5-7個工作日日出示結論匯報(時間從樣本抵達試驗室第二天開始),受托人可視性具體情況決定是否申請辦理急件服務項目,急件更快6鐘頭結果出來。

親子鑒定一直是一個備受爭議的話題,其實它也有一些非...[詳細]

孕期是一段充滿期待和關注的時期,對于一些有疑問的家...[詳細]

當今社會,科技的進步,懷孕期間孕婦親子鑒定也成為一...[詳細]

胎兒孕期親子鑒定是一種非常先進的技術,它解決了傳統...[詳細]

在人生的青春發育期,我們有了豐富多彩資本和機遇嘗試...[詳細]

孕期是一段充滿期待和關注的時期,對于一些有疑問的家...[詳細]

傳統親子鑒定往往需要等候嬰兒出生后即可進行,這會讓...[詳細]

崇左孕期無創親子鑒定是一種高新科技先進技術,能夠在...[詳細]

個人DNA親子鑒定是沒有法律效力的DNA親子鑒定,...[詳細]

個人隱私和親子鑒定是兩種不同的范圍,但是它們都有一...[詳細]

崇左江州做親子鑒定地址查詢...[詳細]

寧明做親子鑒定地址查詢...[詳細]

扶綏做親子鑒定地址在哪里...[詳細]

大新親子鑒定中心鑒定地址...[詳細]

天等做親子鑒定地址電話...[詳細]

崇左做親子鑒定中心地址...[詳細]

憑祥親子鑒定機構地址查詢...[詳細]

龍州正規親子鑒定機構地址在哪里...[詳細]
推薦檢測中心